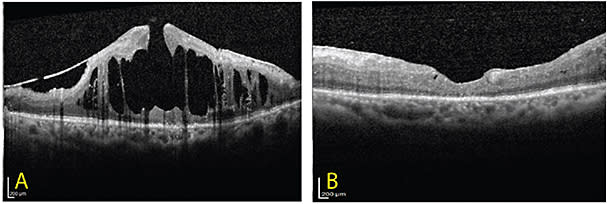

An Evolving Treatment Paradigm for Diabetic Macular Edema
An overview of how pharmacotherapy has changed treatment, with three case studies.
ARASH MOZAYAN, MD • FRANK TSAI, MD • ERIC NUDLEMAN, MD, PhD
Diabetes affects 25.8 million Americans and has become the leading cause of blindness in the working-age population.1 Approximately one million Americans, or 3.8% of diabetics older than 40 years of age, suffer from visual morbidity due to diabetic macular edema.2 The ETDRS demonstrated that focal laser for DME effectively halved the percentage of eyes that experienced vision loss and doubled the percentage of eyes that achieved visual gain.3 Until the last decade, focal laser photocoagulation was the standard of care for treating DME.
The development of anti-VEGF therapy has revolutionized the treatment for DME.4-7 The first prospective study to compare laser monotherapy to combined laser and anti-VEGF was undertaken by the DRCRnet.8 Intravitreal ranibizumab (Lucentis, Genentech, South San Francisco, CA) with prompt vs deferred focal/grid laser was shown to be superior to laser alone.
Subsequently, the RESTORE study directly compared ranibizumab monotherapy or in combination with focal laser to focal laser alone.9 It demonstrated that ranibizumab monotherapy or the combination was superior to laser monotherapy in VA gains and in reducing central retinal thickness. Furthermore, at one year, no differences were detected between the ranibizumab and ranibizumab/laser arms.
RIDE and RISE evaluated monthly ranibizumab monotherapy vs sham over 24 months and showed a 20-30% increase in ≥15-letter gains in treated eyes, compared to sham.10
Arash Mozayan, MD, and Frank Tsai, MD, are vitreoretinal surgery fellows, and Eric Nudleman, MD, PhD, serves on the faculty of Shiley Eye Institute and Jacobs Retina Center of the University of California, San Diego, in La Jolla. None of the authors reports any financial interests in products mentioned in this article. Dr. Mozayan can be reached at sandiegoretina@gmail.com.
VISTA and VIVID were similarly matched studies that compared aflibercept (Eylea, Regeneron, Tarrytown, NY) to macular laser for DME, and they demonstrated more than a 10-letter mean improvement in VA in the aflibercept group, compared to the laser group.6
These data led to FDA approval to treat DME of ranibizumab in 2012 and of aflibercept in 2014, rapidly shifting anti-VEGF therapy to the standard of care, first-line treatment for center-involving DME.
Although anti-VEGF is effective for most patients, refractory macular edema occurs in one-quarter of eyes despite treatment.10,11 Inflammation plays a significant role in the pathophysiology of diabetes.12-15 Evidence has suggested that the release of inflammatory cytokines, including interleukin 1β and tumor necrosis factor (TNF) α, contributes to dysfunction of endothelial tight junctions, resulting in macular edema.16-19
Consistent with these findings, steroids have been shown to be effective for treating macular edema.20-23 All steroid formulations, however, accelerate cataract formation, and they also carry the risk of increased intraocular pressure.
Two intravitreal steroid implantable devices gained FDA approval for the treatment of DME in 2014. The MEAD study demonstrated that treatment with a 0.7-mg dexamethasone intravitreal implant (Ozurdex, Allergan, Irvine, CA) every six months (as needed) resulted in approximately 10% more eyes achieving ≥15-letter gains over sham.24
Similarly, in the FAME study, yearly treatment (as needed) with the 0.2 μg/d fluocinolone acetonide (Iluvien, Alimera Sciences, Alpharetta, GA) implant showed nearly 10% more eyes achieving ≥15-letter gains over sham. Cataracts were common in both studies by one year, but the fluocinolone implant had a higher rate of incisional glaucoma surgery (3.7% in the FDA-approved 0.2 μg/d group) than the dexamethasone implant (0.6% in the FDA-approved 0.7-mg group). The FAME study did not require the use of a previous course of steroid without a clinically significant IOP rise, while the current label does to mitigate the risk of IOP-lowering surgery.
In some cases, a tractional component may exist that prohibits adequate response to pharmacotherapy. Traction from an epiretinal membrane or a taut internal limiting membrane can contribute to DME through tangential forces.25,26 Surgical approaches in such cases have been shown to be effective in improving both vision and structural outcomes.27-31 Evidence has suggested that vitrectomy for nontractional DME provides marginal benefits.32,33
CASE STUDIES
Here we present a series of three patients with DME to illustrate the current available treatment options.
Case 1
A 51-year-old man with a history of diabetes for 10 years presented with decreased vision in the left eye for several months. His most recent hemoglobin A1c was 8.9%. Best-corrected VA was 20/63 in the left eye. The anterior-segment exam was significant for mild nuclear sclerosis.
Dilated funduscopic examination showed severe nonproliferative diabetic retinopathy and clinically significant macular edema of the left eye (Figure 1A). Fluorescein angiography showed diffuse leakage of the macula (Figure 1B), and spectral-domain optical coherence tomography demonstrated intraretinal fluid (Figure 1C). The patient was treated with four monthly intravitreal ranibizumab injections, after which the DME significantly improved (Figure 1D) with VA recovering to 20/25.

Figure 1. A) Multicolor fundus photograph of the left eye with severe NPDR and DME. B) Fluorescein angiogram of the left eye showing diffuse macular leakage. C) OCT of the left eye at presentation with severe intraretinal fluid. D) Resolution of intraretinal fluid after four monthly intravitreal ranibizumab injections.
Case 2
A 60-year-old woman with a history of diabetes for 20 years presented with complaints of decreased vision in her left eye for many years. She had a history of PDR that required panretinal photocoagulation (Figure 2A, page 58). In addition, she had a history of DME previously treated with focal laser and monthly injections of ranibizumab over one year, with improvement in her vision from 20/100 to 20/60.

Figure 2. A) Color fundus photograph of left eye showing scattered microaneurysms, peripapillary flame-shaped hemorrhage, and focal laser scars. B) Fluorescein angiogram of left eye showing diffuse macular leakage. C) OCT of left eye showing persistent IRF after 1 year of monthly intravitreal ranibizumab injections. D) Resolution of IRF shown 3 months after intravitreal dexamethasone implant.
The patient remained at 20/60 with refractory edema despite continued treatment with monthly anti-VEGF therapy for 3 months (Figures 2B and 2C). To address the persistent edema, the patient was treated with an intravitreal dexamethasone implant. One month following treatment, the intraretinal fluid improved, and the patient achieved VA of 20/40, further improving to 20/30 at months 2 and 3 (Figure 2D).
Case 3
A 52-year-old woman was referred following vitrectomy for a diabetic tractional retinal detachment in the left eye. Her VA at presentation was 20/640. Her examination demonstrated DME with an ERM, which was confirmed by OCT (Figure 3A). She had been previously treated with anti-VEGF and intravitreal steroids without improvement.
Figure 3. A) OCT of left eye showing severe IRF with an ERM. (B) Resolution of IRF after vitrectomy with membrane peel.
Due to the evidence of an ERM with traction, the patient underwent a vitrectomy with membrane peel. The macular edema improved significantly by one month postoperatively, and she achieved VA of 20/250 (Figure 3B).
DISCUSSION
Here, we presented three patients with DME treated by a sequential approach. In the majority of eyes, anti-VEGF therapies have surpassed focal laser as the preferred first-line treatments for DME with center involvement. In refractory cases, steroids can offer an effective option; however, in advanced cases of diabetic eye disease, fibrosis can contribute significantly, necessitating a surgical approach to relieve the traction and improve the edema.
It is an exciting era in the treatment of DME, with effective therapies shifting our treatment paradigms.34-36 New approaches are also providing promising advances. Inflammatory inhibitors, such as an ophthalmic suspension of loteprednol etabonate (Lotemax, Bausch + Lomb, Rochester, NY) and oral minocycline, are currently in early clinical trials.37 Targets that modulate the blood-retinal barrier, such as inhibition of kallikrein, insulin-like growth factor 1, integrins, and upregulation of Tie2, are under investigation.
In addition, new data comparing the three major anti-VEGF drugs in DME will soon become available. With a growing population affected by diabetes, the demand for better treatments for DME will continue to rise. RP
REFERENCES
1. Centers for Disease Control and Prevention. National diabetes fact sheet: national estimates and general information on diabetes and prediabetes in the United States. Atlanta, GA; 2011.
2. Varma R, Bressler NM, Doan QV, et al. Prevalence of and risk factors for diabetic macular edema in the United States. JAMA Ophthalmol. 2014;132:1334-1340.
3. Photocoagulation for diabetic macular edema. Early Treatment Diabetic Retinopathy Study report number 1. Early Treatment Diabetic Retinopathy Study research group. Arch Ophthalmol. 1985;103:1796-1806.
4. Rajendram R, Fraser-Bell S, Kaines A, et al. A 2-year prospective randomized controlled trial of intravitreal bevacizumab or laser therapy (BOLT) in the management of diabetic macular edema: 24-month data: report 3. Arch Ophthalmol. 2012;130:972-979.
5. Do DV, Nguyen QD, Shah SM, et al. An exploratory study of the safety, tolerability and bioactivity of a single intravitreal injection of vascular endothelial growth factor Trap-Eye in patients with diabetic macular oedema. Br J Ophthalmol. 2009;93:144-149.
6. Korobelnik J-F, Do DV, Schmidt-Erfurth U, et al. Intravitreal aflibercept for diabetic macular edema. Ophthalmology. 2014;121:2247-2254.
7. Virgili G, Parravano M, Evans JR, et al. Anti-vascular endothelial growth factor for diabetic macular oedema. Cochrane Database Syst Rev. 2014;10:CD007419.
8. Diabetic Retinopathy Clinical Research Network; Elman MJ, Aiello LP, Beck RW, et al. Randomized trial evaluating ranibizumab plus prompt or deferred laser or triamcinolone plus prompt laser for diabetic macular edema. Ophthalmology. 2010;117:1064-1077.e35.
9. Mitchell P, Bandello F, Schmidt-Erfurth U, et al. The RESTORE study: ranibizumab monotherapy or combined with laser versus laser monotherapy for diabetic macular edema. Ophthalmology. 2011;118:615-625.
10. Nguyen QD, Brown DM, Marcus DM, et al. Ranibizumab for diabetic macular edema: results from 2 phase III randomized trials: RISE and RIDE. Ophthalmology. 2012;119:789-801.
11. Brown DM, Nguyen QD, Marcus DM, et al. Long-term outcomes of ranibizumab therapy for diabetic macular edema: the 36-month results from two phase III trials: RISE and RIDE. Ophthalmology. 2013;120:2013-2022.
12. Antonetti DA, Klein R, Gardner TW. Diabetic retinopathy. N Engl J Med. 2012;366:1227-1239.
13. Wang K, Wang Y, Gao L, Li X, Li M, Guo J. Dexamethasone inhibits leukocyte accumulation and vascular permeability in retina of streptozotocin-induced diabetic rats via reducing vascular endothelial growth factor and intercellular adhesion molecule-1 expression. Biol Pharm Bull. 2008;31:1541-1546.
14. Tamura H, Miyamoto K, Kiryu J, et al. Intravitreal injection of corticosteroid attenuates leukostasis and vascular leakage in experimental diabetic retina. Invest Ophthalmol Vis Sci. 2005;46:1440-1444.
15. Antonetti DA, Wolpert EB, DeMaio L, Harhaj NS, Scaduto RC Jr. Hydrocortisone decreases retinal endothelial cell water and solute flux coincident with increased content and decreased phosphorylation of occludin. J Neurochem. 2002;80:667-677.
16. Grigsby JG, Cardona SM, Pouw CE, et al. The role of microglia in diabetic retinopathy. J Ophthalmol. 2014:705783.
17. Ibrahim AS, El-Remessy AB, Matragoon S, et al. Retinal microglial activation and inflammation induced by amadori-glycated albumin in a rat model of diabetes. Diabetes. 2011;60:1122-1133.
18. Joussen AM, Poulaki V, Mitsiades N, et al. Nonsteroidal anti-inflammatory drugs prevent early diabetic retinopathy via TNF-alpha suppression. FASEB J. 2002;16:438-440.
19. Funatsu H, Noma H, Mimura T, Eguchi S, Hori S. Association of vitreous inflammatory factors with diabetic macular edema. Ophthalmology. 2009;116:73-79.
20. Gillies MC, Sutter FK, Simpson JM, Larsson J, Ali H, Zhu M.. Intravitreal triamcinolone for refractory diabetic macular edema: two-year results of a double-masked, placebo-controlled, randomized clinical trial. Ophthalmology. 2006;113:1533-1538.
21. Martidis A, Duker JS, Greenberg PB, et al. Intravitreal triamcinolone for refractory diabetic macular edema. Ophthalmology. 2002;109:920-927.
22. Jonas JB, Kreissig I, Söfker A, Degenring RF, et al. Intravitreal injection of triamcinolone for diffuse diabetic macular edema. Arch Ophthalmol. 2003;121:57-61.
23. Massin P, Audren F, Haouchine B, et al. Intravitreal triamcinolone acetonide for diabetic diffuse macular edema: preliminary results of a prospective controlled trial. Ophthalmology. 2004;111:218-224; discussion 224-225.
24. Boyer DS, Yoon YH, Belfort R, et al. Three-year, randomized, sham-controlled trial of dexamethasone intravitreal implant in patients with diabetic macular edema. Ophthalmology. 2014;121:1904-1914.
25. Flaxel CJ, Edwards AR, Aiello LP, et al. Factors associated with visual acuity outcomes after vitrectomy for diabetic macular edema: diabetic retinopathy clinical research network. Retina. 2010;30:1488-1495.
26. Jumper JM, Embabi SN, Toth CA, McCuen BW II, Hatchell DL. Electron immunocytochemical analysis of posterior hyaloid associated with diabetic macular edema. Retina. 2000;20:63-68.
27. Almony A, Holekamp NM, Bai F, Shui YB, Beebe D. Small-gauge vitrectomy does not protect against nuclear sclerotic cataract. Retina. 2012;32:499-505.
28. Harbour JW, Smiddy WE, Flynn HW Jr, Rubsamen PE. Vitrectomy for diabetic macular edema associated with a thickened and taut posterior hyaloid membrane. Am J Ophthalmol. 1996;121:405-413.
29. Kumagai K, Furukawa M, Ogino N, Larson E, Iwaki M, Tachi N. Long-term follow-up of vitrectomy for diffuse nontractional diabetic macular edema. Retina. 2009;29:464-472.
30. Lewis H, Abrams GW, Blumenkranz MS, Campo RV. Vitrectomy for diabetic macular traction and edema associated with posterior hyaloidal traction. Ophthalmology. 1992;99:753-759.
31. Pendergast SD, Hassan TS, Williams GA, et al. Vitrectomy for diffuse diabetic macular edema associated with a taut premacular posterior hyaloid. Am J Ophthalmol. 2000;130:178-186.
32. Patel JI, Hykin PG, Schadt M, et al. Diabetic macular oedema: pilot randomised trial of pars plana vitrectomy vs macular argon photocoagulation. Eye (Lond). 2006;20:873-881.
33. Thomas D, Bunce C, Mourman C, Laidlaw DAH. A randomised controlled feasibility trial of vitrectomy versus laser for diabetic macular oedema. Br J Ophthalmol. 2005;89:81-86.
34. Mitchell P, Wong TY; Diabetic Macular Edema Treatment Guideline Working Group. Management paradigms for diabetic macular edema. Am J Ophthalmol. 2014;157:505-513.
35. Thomas BJ, Shienbaum G, Boyer DS, Flynn HW Jr. Evolving strategies in the management of diabetic macular edema: clinical trials and current management. Can J Ophthalmol. 2013;48:22-30.
36. Jusufbegovic D, Mugavin MO, Schaal S. Evolution of controlling diabetic retinopathy: changing trends in the management of diabetic macular edema at a single institution over the past decade. Retina. 2015 Jan 14. [Epub ahead of print]
37. Cukras CA, Petrou P, Chew EY, Meyerle CB, Wong WT. Oral minocycline for the treatment of diabetic macular edema (DME): results of a phase I/II clinical study. Invest Ophthalmol Vis Sci. 2012;53:3865-3874.








